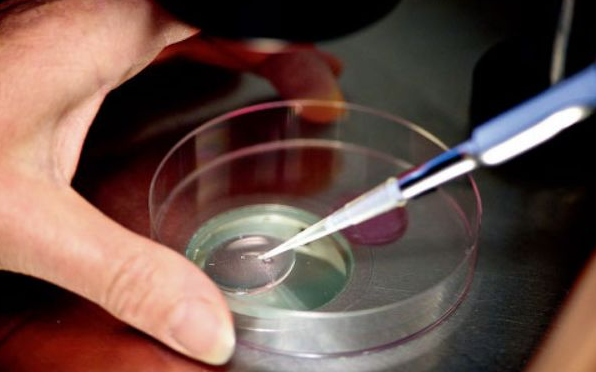

初步咨询与方案制定
首先,你需要选择一家信誉良好的医院进行初步咨询。长沙拥有许多优质的试管婴儿机构,比如湖南省妇幼保健院、长沙市中医药大学附属医院等。您可以向医生详细询问自己的情况,包括年龄、身体状况、生育需求等,医生会根据您的具体情况制定个性化的方案。 咨询过程中,您还可以了解相关费用、流程等信息,以便做出更明智的决定。
体检与检查
在确定方案后,需要进行一系列体检和检查,包括血液常规、激素水平检测、染色体分析等。这些检查是为了了解您的身体状况,以及是否有潜在的遗传风险。对于女性来说,还会进行卵巢功能检查、子宫内膜厚度测量等。 医生会根据检查结果评估您的生育能力,并制定相应的治疗方案。
促排卵与取卵
如果检查结果良好,下一步便是促排卵阶段。医生会通过注射促排卵药物帮助您促进卵巢内卵泡发育成熟。在药物作用下,您的身体会在一定时间内产生多个成熟的卵子。取卵手术一般是在超声引导下进行,操作过程简短无痛感,术后恢复很快。
精液检查与胚胎培养
在您进行促排卵的同时,男方需要进行精液检查,评估精子的数量、活力和形态。优质的精子会与成熟的卵子结合形成胚胎。受精过程可以采用体外受精(IVF)方式,将精子和卵子在一个培养皿中混合在一起。在实验室条件下,受精后的胚胎会进行培养,筛选出发育状况良好的胚胎。
胚胎移植
经过几天的胚胎培养后,医生会将筛选出的优质胚胎移植到您的子宫内。移植过程也是微创手术,操作简单快捷,术后恢复快。移植成功后,需要进行一段时间的休息和观察,大约两周后就可以进行妊娠测试。
孕期管理与产检
如果妊娠测试结果为阳性,恭喜您成功怀孕了!接下来需要定期进行产检,监测胎儿发育状况,并接受医生的指导和建议。整个孕期都需要保持良好的生活习惯,避免接触有害物质,保证营养均衡,才能确保母婴健康安全。
结语
长沙单身女性做试管婴儿的流程相对复杂,需要经过多步骤的检查、治疗和管理。选择一家信誉良好的医院,积极配合医生的指导,并保持良好的心态和生活习惯,都有助于提高成功率。希望以上信息能帮助您了解长沙单身女性进行试管婴儿所需要的步骤,祝您早日实现生育梦想。


还没有内容